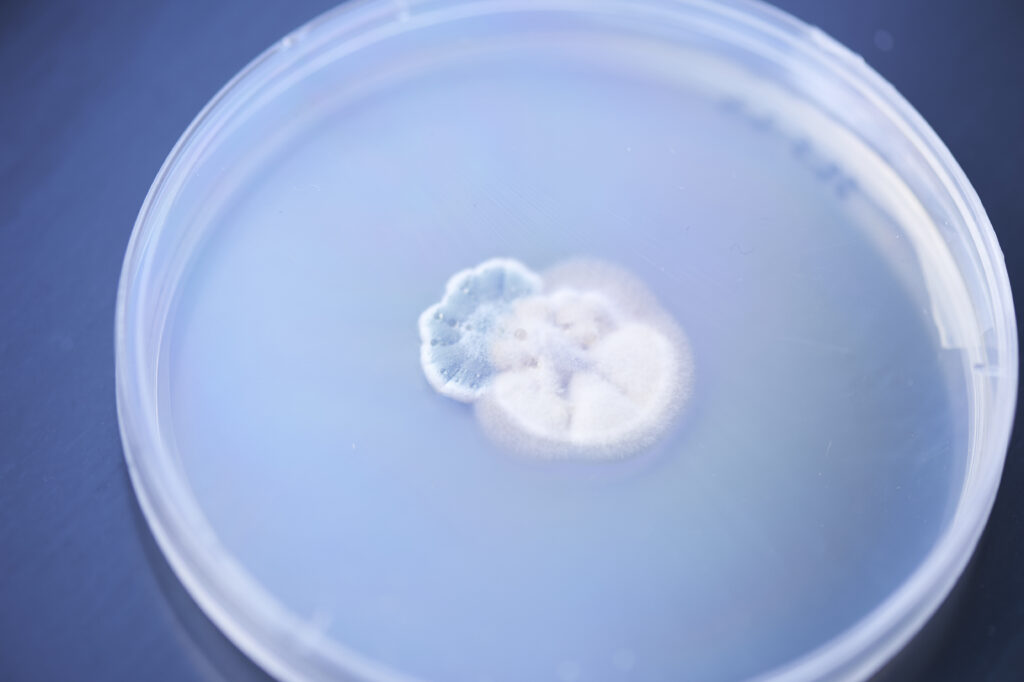

KOKON UW – ważne filmy i pogłębione rozmowy o współczesności
Przegląd filmów o nauce wraca na Uniwersytet Warszawski w dniach 18-20 marca 2026 r. Gośćmi specjalnymi drugiej edycji będą Erik Gandini oraz Wojciech Marczewski. Każdy dzień przeglądu ma swój tytuł-hasło: PRACA, EKSPERYMENT i OPARTE NA FAKTACH.
Podsumowanie I Ogólnopolskiej Konferencji Sieciującej Akademickie Inkubatory Przedsiębiorczości
Blisko 70 uczestników reprezentujących ponad 50 ośrodków akademickich z całego kraju. Dwa dni rozmów o rozwoju, inspirujących dyskusji i wymiany doświadczeń.
Akademia Przedsiębiorczości
Intensywny obóz dla studentów i doktorantów Uniwersytetu Warszawskiego, Warszawskiego Uniwersytetu Medycznego oraz…
Nauka Sprawdza
Nauka opiera się na faktach, pozostaje niezależna od indywidualnych opinii. W świecie…
Mentoring UW
Program Mentoring UW to inicjatywa wspierająca studentów i doktorantów w realizacji ich…
Tydzień Noblowski UW
Spotkania ekspertów z UW, podczas których na bieżąco komentowane są nominacje i…
Nabór na granty „Nauka Sprawdza” – zdobądź 20 tysięcy!
Dołącz do badaczy, którzy analizują dezinformację dotyczącą nauki. Odkrywaj, co i jak komunikują media i instytucje, jak reagują odbiorcy i…
#UWagaNauka – 19 maja 2026
Okrągła, piąta edycja będzie przestrzenią wymiany doświadczeń i prezentacji praktyk, które wspierają rzetelną i atrakcyjną komunikację naukową. Zaproszeni Goście -…
IV Targi Kół Naukowych UW za nami!
Po raz kolejny wraz z Samorządem Studentów Uniwersytetu Warszawskiego oraz Radą Organizacji Naukowych, Społecznych i Artystycznych zorganizowaliśmy Targi Kół Naukowych UW –…
Inauguracja 6. edycji programu Mentoring UW za nami!
Wczoraj w Muzeum Uniwersytetu Warszawskiego odbyła się uroczysta inauguracja 6. edycji programu Mentoring UW, realizowanego we współpracy Inkubatora UW i…
KOKON UW – przegląd filmów o nauce
Rozpoczęliśmy drugą edycję wydarzenia zapoczątkowanego w zeszłym roku. Przegląd odbywa się w Bibliotece Uniwersyteckiej w Warszawie i potrwa do 20…
15 edycji odwagi i innowacji. BraveCamp z jubileuszową galą finałową!
Za nami gala finałowa 15. edycji BraveCamp – Akademii Przedsiębiorczości Inkubatora Uniwersytetu Warszawskiego. Tydzień intensywnej pracy młodych innowatorów zwieńczył wieczór…
Premiera raportu „Just Start: BraveCamp Akademia Przedsiębiorczości Studenckiej 2017–2025”
Często podnoszonym wyzwaniem polskiej edukacji jest nauka przedsiębiorczości. Jak przekazać wiedzę i umiejętności, by skutecznie obudzić w młodych zapał do…
Kino i nauka
Przegląd filmów o nauce KOKON tworzy przestrzeń dojrzewania i wykluwania…
#UWagaNauka
Projekt #UWaga Nauka powstał w celu wymiany dobrych praktyk i…
Koła Naukowe
Na Uniwersytecie Warszawskim działa prawie 230 kół naukowych i do…
Program stażowy
Zapraszamy studentów i studentki UW oraz WUM do wzięcia udziału w rekrutacji na płatny staż w firmie Pfizer Polska. Dotychczas…
OGUNy
Inkubatorowe OGUN-y to wejście w świat przedsiębiorczości, nowych technologii, samorozwoju i zarządzania projektami. Ale nie jest to wejście, do którego…
Zostań ekspertem IUW
Zostań Ekspertem Inkubatora UWSpołeczność Inkubatora UW to również eksperci mający wiedzę i doświadczenie, którym chcą się podzielić ze studentami będącymi…
Nice Talk! O biznesie przy kawie
Połączenie kameralnych rozmów i inspirującego networkingu. Nice talk! to wydarzenie, w którym studenci i doktoranci Uniwersytetu Warszawskiego oraz Warszawskiego Uniwersytetu…
Starter
Kurs STARTER pozwala rozwinąć pomysł i przekształcić go w gotowy do wdrożenia projekt biznesowy. Od postawy przedsiębiorczej, przez analizę rynku,…
Wisła na rozdrożu
Wisła na Rozdrożu to wyjątkowe wydarzenie, które łączy siły studentów Uniwersytetu Warszawskiego i Uniwersytetu Jagiellońskiego w dyskusji o wyzwaniach ekologicznych.…